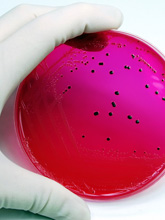

The advice hub Salmonella
We frequently get calls from concerned owners about the risks of getting Salmonella from their chickens and eggs.
What exactly is Salmonella?
Salmonella is a bacteria which can infect both animals and humans. There are many species of Salmonella, all of which have a preferred animal to infect, for example, Salmonella Dublin prefers to live in cattle. Not all Salmonella cause illness and not all Salmonella which causes disease in one animal will go on to cause disease in another. But whilst most Salmonella species prefer to infect a particular type of animal they can infect other animals and humans. For example, Salmonella Enteritidis prefers to infect chickens but causes no problems for them. However, it can occasionally go on to infect people causing vomiting and diarrhoea.
What are the signs of Salmonella?
Salmonella can cause vomiting and diarrhoea in people and in extreme cases, causes blood poisoning. In animals it can cause diarrhoea and blood poisoning.
Can Salmonella cause illness in my chickens?
Yes, it is indeed possible for Salmonella to cause disease in chickens; however this is extremely rare. There are two main species involved: S. Pullorum and S. Gallinarum. S. Pullorum can cause blood poisoning, diarrhoea and sudden death in young chicks (under three weeks of age). S. Gallinarum can cause sudden death, diarrhoea and difficulty breathing.
Can chickens carry Salmonella species which can cause illness in me and my family?
Whilst it is not particularly common, Salmonella can cause illness in people, especially if they are vulnerable, such as people with HIV and pregnant women.
There are two species of Salmonella which chickens can carry which can cause illness in people S. Enteritidis and S. Typhimurium. These species do not cause illness in chickens but can in extreme cases infect people. In the 1980’s, Edwina Currie caused a storm by claiming that most UK eggs had Salmonella. This caused a plummet in egg sales and subsequently the egg industry began to routinely test all egg and meat producing chickens regularly. All commercial laying flocks in the UK are now vaccinated for these strains of Salmonella therefore the incidence is very rare.
How do people get Salmonella from their birds?
Most people contract the bacteria from not washing their hands properly after handling their birds, or from dirty eggs coming into contact with other foods in the kitchen.
How can I reduce the risk of Salmonella in my birds?
Rodents and wild birds are potential carriers so ensure you control rats with bait stations and keep feed in secure containers.
Use Beryl’s Friendly Bacteria - the 200 species of friendly bacteria in this product compete for space in the gut with harmful bacteria such as Salmonella being excluded.
Chicken Vet Digesti-Health can be given daily in feed to help exclude Salmonella as it binds to the bacteria stopping it attaching to your chickens intestine.
Do I need to vaccinate my birds?
There is no real need to vaccinate your birds provided that you wash your hands properly after handling your chickens and that you cook your food properly.
If you are buying in point of lay pullets form an experienced pullet rearer it is likely they will be vaccinated for salmonella – just ask.
If you do wish to vaccinate your chickens then it will involve giving your birds two injections 4 weeks apart followed by an annual booster. The problem is that vaccination only protects against Enteritidis and Typhimurium and not all the other potential strains out there. Vaccine is only available in 1000 doses so this is a very expensive option.
Can I test my birds?
You can test your birds for Salmonella with faecal samples. You can request this through your own vet.
If I wish to sell my eggs do I need to test my chickens for Salmonella?
If you have less than 50 birds you can sell eggs at your gate or locally door to door.
However, if you sell eggs to someone who will sell them on, such as a shopkeeper, hotelier etc, you need to register with DEFRA. For more details see the DEFRA website.


